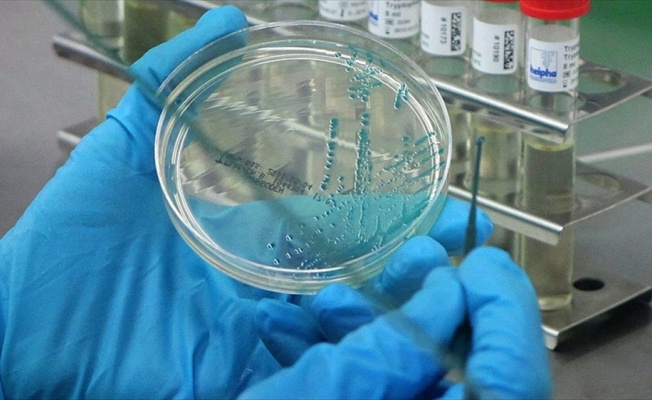

ANKARA (AA) - Bilim adamları, bakterilerin dokunma duyusuna sahip olduğunu ortaya çıkardı.
İsviçre'nin Basel Üniversitesi araştırmacıları, bakterilerin yalnızca kimyasal sinyallere yanıt vermediğini, aynı zamanda dokunma duyusuna da sahip olduklarını belirledi.
Araştırmacılar, klasik anlamda herhangi bir duyu organına sahip olmayan bakterilerin, yüzeyleri nasıl tanıdıklarını ve mekanik uyarıya saniyeler içince nasıl yanıt verdiklerini gözlemledi.
Çalışmayı yöneten Prof. Dr. Jurs Jenal, "Patojen olmayan Caulobacter bakterilerini model olarak kullanan ekibimiz, ilk kez bakterilerin bir ‘dokunma duyusuna' sahip olduklarını ortaya koydu. Bu mekanizma, bakterilerin yüzeyleri tanımalarını sağlıyor ve hücrenin kendi ani yapışkanını üretmesine neden oluyor." dedi.
Araştırmacılar, yüzen Caulobacter'in hücre zarlarında bakterinin sıvı içinde ilerlemesini sağlayan “flagellum” adlı ve dönen motora benzeyen bir yapıları olduğunu buldu. Flagellum'un, iyon kanalları yoluyla hücre içine doğru oluşan proton akışından güç kazandığı belirlendi.
Yüzen hücreler bir yüzeye dokunduğunda bu yapının etkilendiğine ve proton akışının kesintiye uğradığına işaret eden araştırmacılar, böylece birkaç saniyede bakterilerin yüzeye sağlam şekilde sabitlenmesine olanak tanıyan yapışkan bir maddenin salgılandığını vurguladı.
Jenal, "Bu durum, bakterilerin bir yüzeyle karşılaştığında davranışlarını nasıl bir anda ve belirgin bir biçimde değiştirdiğini açıklıyor." dedi.
Muhabir: Zehra Ulucak











